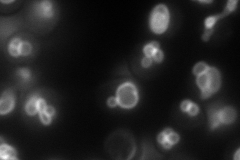
YOR270C
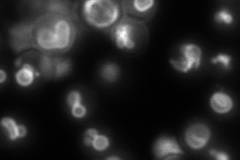
YOR270C
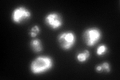
YOR270C

View description
Subunit a of vacuolar-ATPase V0 domain, one of two isoforms (Vph1p and Stv1p); Vph1p is located in V-ATPase complexes of the vacuole while Stv1p is located in V-ATPase complexes of the Golgi and endosomes
Localization:
Intensity:
Fold change:
Significance:
-
C’ GFP library in SD

vacuole membrane266.7 -
N' NOP1pr-GFP in SD
vacuole membrane190.057 -
N' TEF2pr-mCherry in SD

vacuole membrane82.0716 -
N' NATIVEpr-GFP in SD
vacuole membrane250.762 -
N' TEF2pr-VC and Cyto-VN in SD

vacuole membrane37.5718 -
C’ GFP library in SD+DTT
vacuole membrane223.970.83No -
C’ GFP library in SD+H2O2

vacuole membrane227.160.85No -
C’ GFP library in Starvation Media

vacuole membrane324.431.21No -
C’ GFP library on the background of Pup2-DaMP

vacuole membrane -
C’ GFP library on the background of CCT mutant

vacuole membrane244.4010.91636No
